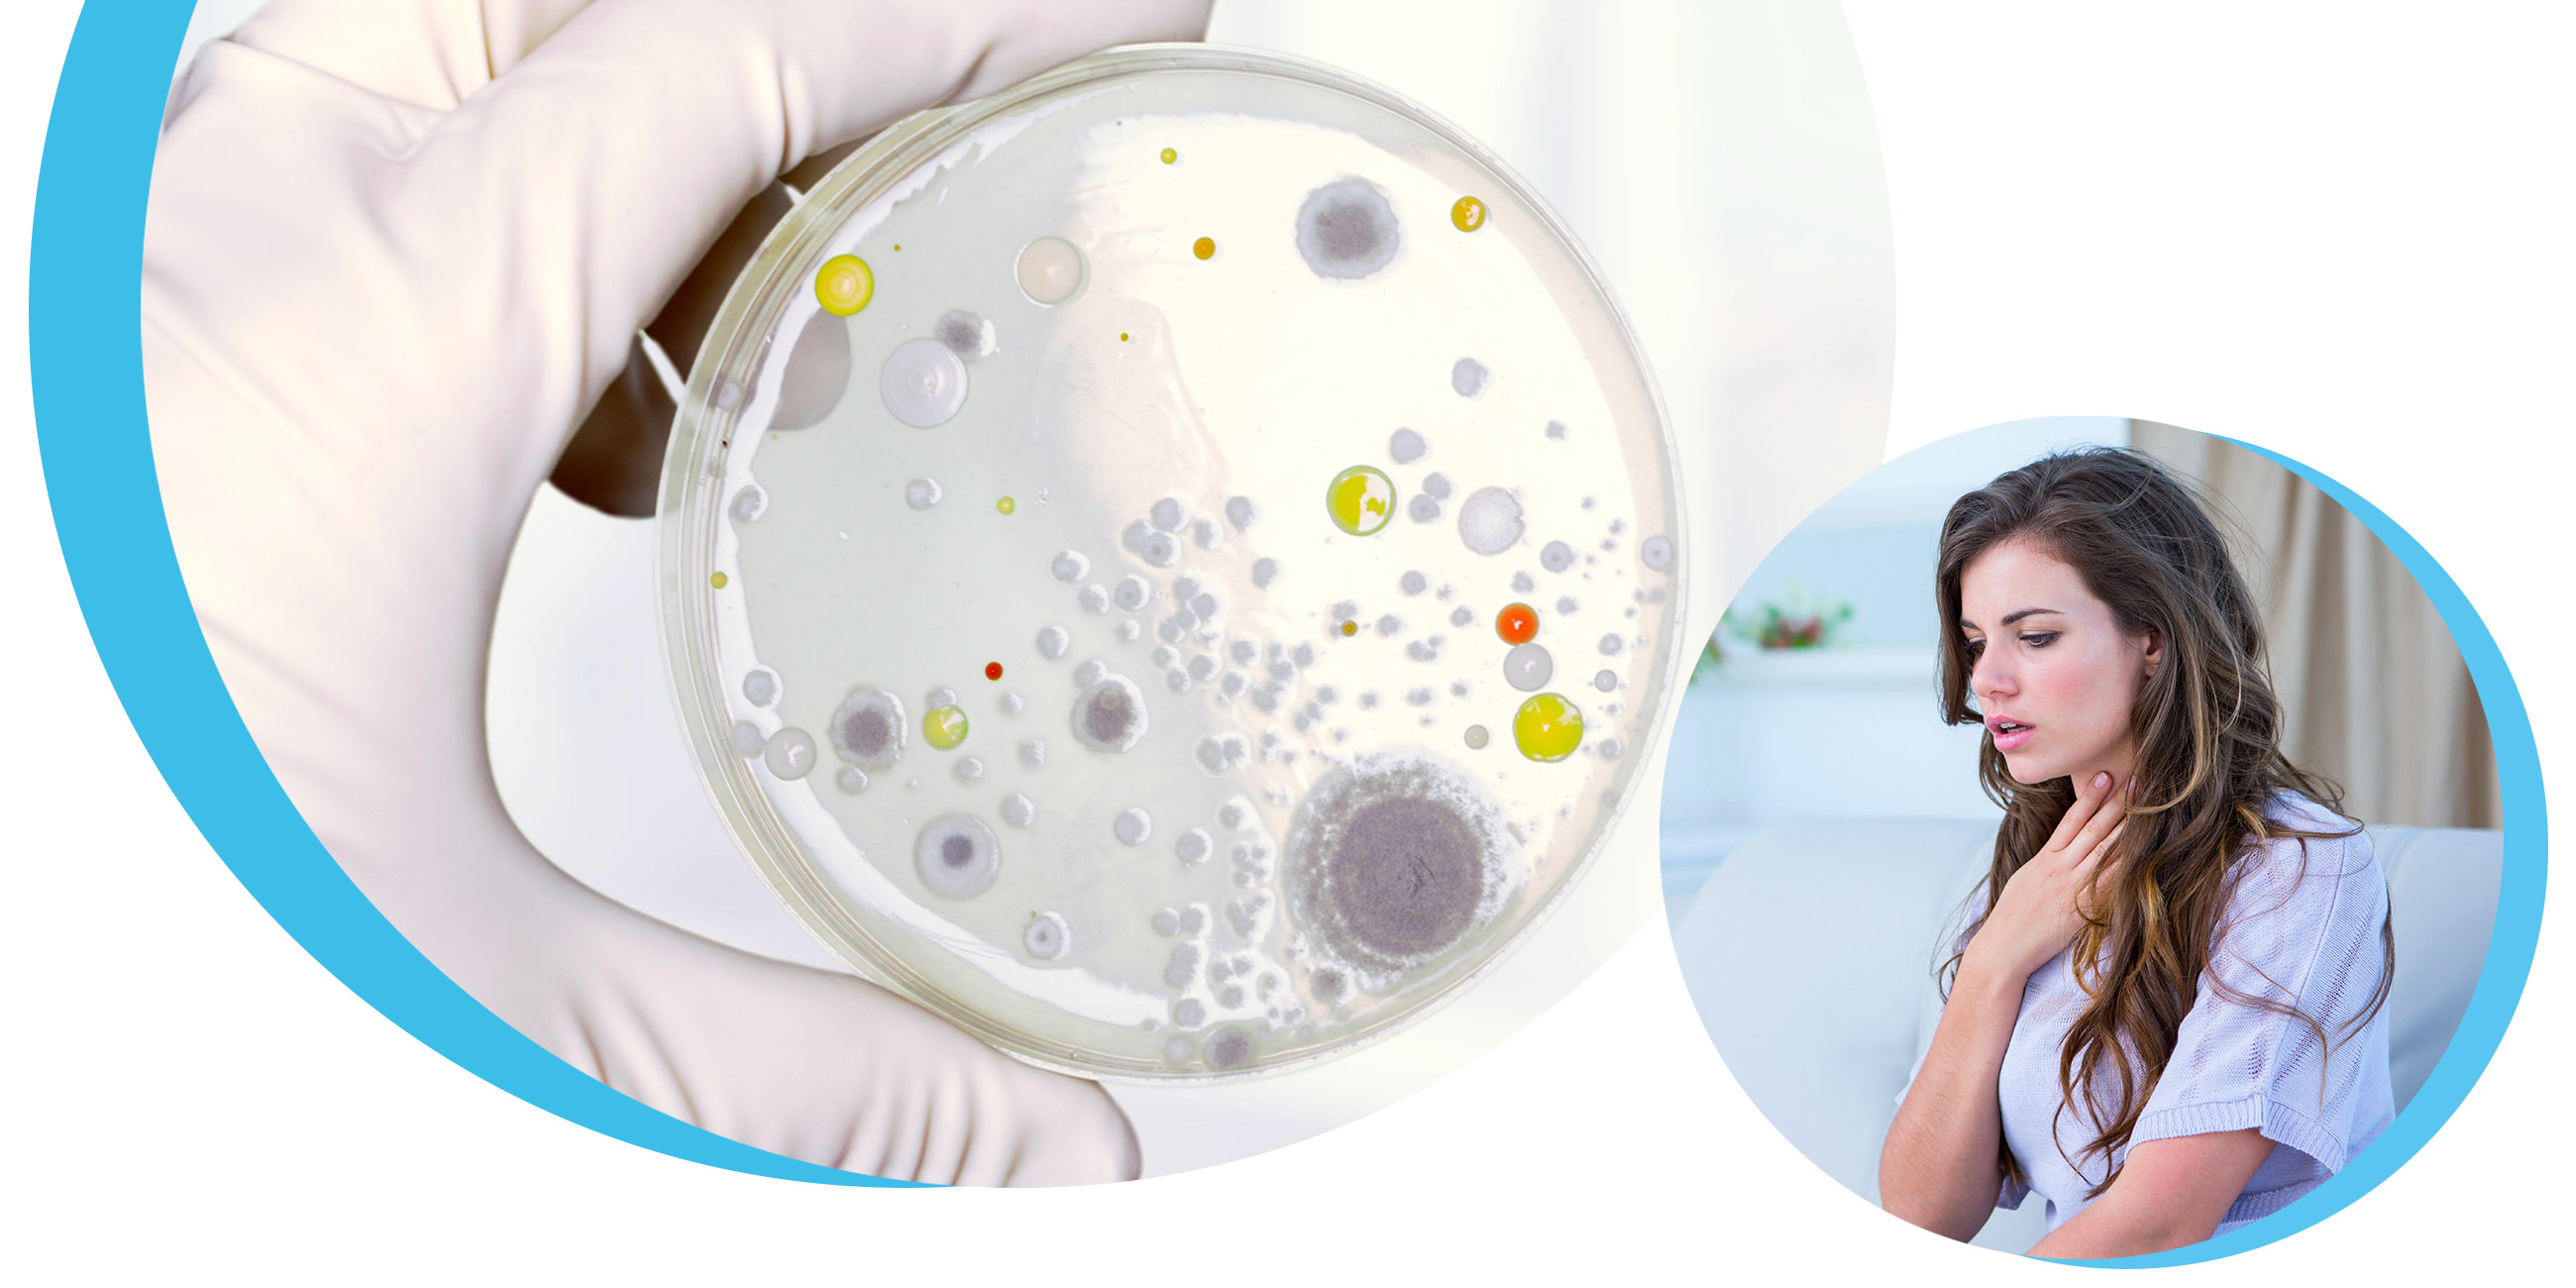

Détection et identification
Repérage de la contamination fongique, matériaux à risque et méthodes d’échantillonnage et d’analyse.

Méthodes de travail sécuritaires
Pratiques sécuritaires, EPI appropriés et contrôle de l’exposition lors des interventions.

Décontamination et prévention
Protocoles de décontamination, contrôle de l’humidité et prévention de la réapparition.

À Propos de l'Expert
Je suis Adnane Ramromi, Directeur Sécurité-Environnement chez Groupe SolAirEau. Mon quotidien ? L'investigation de moisissures et le comptage de fibres d'amiante (reconnu par l'IRSST). Mais ma véritable passion réside dans la transmission. "Ma mission : vous transmettre les outils techniques nécessaires pour maîtriser vos environnements de travail et évoluer avec assurance." Accréditation : Formateur agréé par la CPMT (Commission des partenaires du marché du travail). Expertise Amiante : Compteur de fibres reconnu par l’IRSST. Expertise Moisissures : Investigateur spécialisé en contamination résidentielle. Engagement : Un contenu conçu pour le terrain, axé sur la progression de vos compétences et la sécurité de votre entreprise.
Plan de la formation :
-
1
Introduction aux Moisissures
-
(Included in full purchase)
Bienvenue à la formation
-
(Included in full purchase)
Introduction
-
(Included in full purchase)
Objectif de la formation
-
(Included in full purchase)
Livret de formation
-
(Included in full purchase)
-
2
Généralités sur les moisissures
-
(Included in full purchase)
C’est quoi les moisissures ?
-
(Included in full purchase)
Conditions de croissance et Matériaux favorisant la croissance
-
(Included in full purchase)
Effets indésirables des moisissures
-
(Included in full purchase)
Généralités sur les moisissures
-
(Included in full purchase)
-
3
Investigation
-
(Included in full purchase)
L’investigateur et ses limites
-
(Included in full purchase)
Objectif et étapes 1 et 2 de l’investigation
-
(Included in full purchase)
Objectif et étapes 3 de l’investigation (non-intrusive)
-
(Included in full purchase)
Objectif et étapes 3 de l’investigation (intrusive)
-
(Included in full purchase)
Inspection - EPI : étape 3
-
(Included in full purchase)
INVESTIGATION
-
(Included in full purchase)
-
4
Échantillonnage et tests de laboratoire
-
(Included in full purchase)
Quand est-il nécessaire d’échantillonner et d’analyser au laboratoire ?
-
(Included in full purchase)
1 - Quel type d’échantillon ?
-
(Included in full purchase)
2 - Quel type d’échantillon ?
-
(Included in full purchase)
Quel type d’analyse ?
-
(Included in full purchase)
ECHANTILLONNAGE ET TESTS DE LABORATOIRE
-
(Included in full purchase)
-
5
Réglementation et normes de décontamination
-
(Included in full purchase)
Selon la surface contaminée
-
(Included in full purchase)
Selon la surface contaminée – Norme ACC 2004 / condition de contamination - IICRC
-
(Included in full purchase)
Bonnes pratiques – Avant le début des travaux
-
(Included in full purchase)
Bonnes pratiques – Avant le début des travaux (2)
-
(Included in full purchase)
Bonnes pratiques – Avant le début des travaux (3)
-
(Included in full purchase)
Bonnes pratiques – Avant le début des travaux (4)
-
(Included in full purchase)
Bonnes pratiques – Pendant les travaux (1)
-
(Included in full purchase)
Bonnes pratiques – Pendant les travaux (2)
-
(Included in full purchase)
Bonnes pratiques – Après les travaux
-
(Included in full purchase)
Annexe A : Démarche d’investigation en vue de la décontamination
-
(Included in full purchase)
Annexe E : Processus de réhabilitation du bâtiment à la suite de l’investigation
-
(Included in full purchase)
RÉGLEMENTATION ET NORMES DE DÉCONTAMINATION
-
(Included in full purchase)
-
6
Ne pas confondre les moisissures et la mérule pleureuse
-
(Included in full purchase)
Points importants (1)
-
(Included in full purchase)
Points importants (2)
-
(Included in full purchase)
Points importants (3)
-
(Included in full purchase)
Points importants (4)
-
(Included in full purchase)
NE PAS CONFONDRE LES MOISISSURES ET LA MÉRULE PLEUREUSE
-
(Included in full purchase)
-
7
Conclusion
-
(Included in full purchase)
Conclusion
-
(Included in full purchase)
Quiz de rétroaction
-
(Included in full purchase)
Commencez votre parcours dès aujourd’hui!
Développez vos compétences en matière de sécurité et de gestion des travaux liés à la moisissure.Faites un pas en avant pour transformer votre approche professionnelle.
$399.00